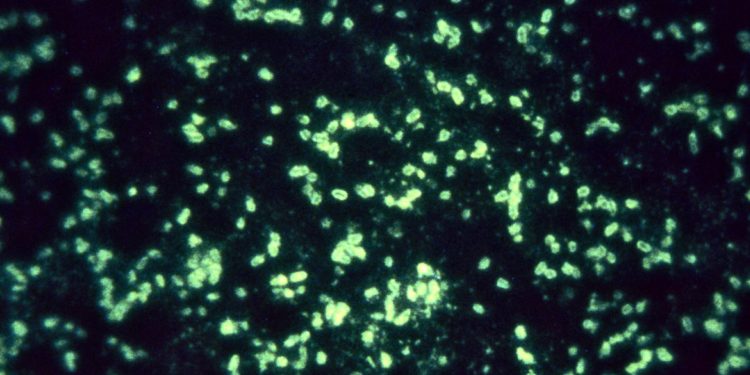

Toronto: Scientists, including one of Indian origin, have isolated the smallest biological molecule to date that they say completely and specifically neutralises the SARS-CoV-2 virus which cause COVID-19.
Ten times smaller than a full-sized antibody, the molecule has been used to construct a drug — known as Ab8 — for potential use as a therapeutic and prophylactic against SARS-CoV-2, according to the study published in the journal Cell.
The researchers, including Sriram Subramaniam from the University of British Columbia in Canada, found that Ab8 is highly effective in preventing and treating SARS-CoV-2 infection in mice and hamsters.
Its tiny size not only increases its potential for diffusion in tissues to better neutralise the virus, but also makes it possible to administer the drug by alternative routes, including inhalation, the researchers said.
The drug does not bind to human cells, which is a good sign that it won’t have negative side-effects in people, they said.
“Ab8 not only has potential as therapy for COVID-19, but it also could be used to keep people from getting SARS-CoV-2 infections,” said study co-author John Mellors, from the University of Pittsburgh in the US.
“Antibodies of larger size have worked against other infectious diseases and have been well tolerated, giving us hope that it could be an effective treatment for patients with COVID-19 and for protection of those who have never had the infection and are not immune,” Mellors said.
The tiny antibody component is the variable, heavy chain (VH) domain of an immunoglobulin, which is a type of antibody found in the blood.
It was found by ‘fishing’ in a pool of more than 100 billion potential candidates using the SARS-CoV-2 spike protein as bait, the researchers said.
Ab8 is created when the VH domain is fused to part of the immunoglobulin tail region, adding the immune functions of a full-size antibody without the bulk, they said.
Clinical trials are testing convalescent plasma — which contains antibodies from people who already had COVID-19 — as a treatment for those battling the infection, but there isn’t enough plasma for those who might need it, and it isn’t proven to work.
The researchers set out to isolate the gene for one or more antibodies that block the SARS-CoV-2 virus, which would allow for mass production.
PTI